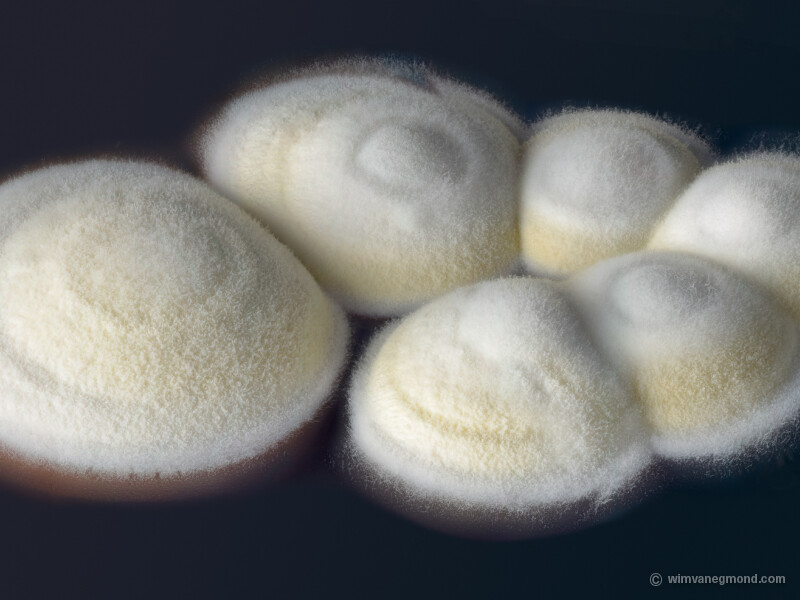

Assignments & Exhibitions
In most cases there is no clear distinction between commisioned work and my own projects. That's because I am usually asked for subjects that have to do with my skills in microscopy and close-up imaging.
This is a selection with examples of exhibitions and assignments. Of course it is fun to work on requested subjects. But there is always the risk that you can't find what you are looking for.
My work is not only about how to make a nice image. It is also a matter of being able to find and collect the organisms. And then it requires a lot of patience to persuade microbes to behave nicely in front of a camera.